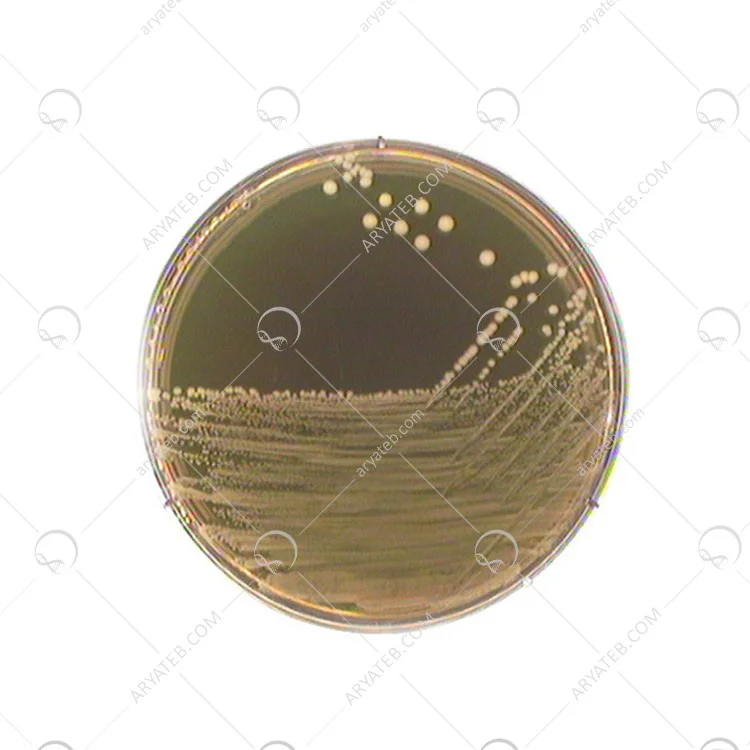

محیط کشت M17 BROTH
محیط کشت m17
محیط کشت M17 Broth یک محیط کشت مایع (براث) غنی شده است که به طور خاص برای کشت، جداسازی و شمارش استرپتوکوکهای لاکتیک (مانند لاکتوکوکوس لاکتیس و استرپتوکوکوس ترموفیلوس) و همچنین برای سنجش باکتریوفاژهای لاکتیک طراحی شده است.
کاربردها:
-
کشت باکتریهای اسید لاکتیک: این محیط به طور گسترده برای رشد و تکثیر استرپتوکوکهای لاکتیک، به ویژه آنهایی که در محصولات لبنی مانند ماست، پنیر و سایر فرآوردههای شیری یافت میشوند، استفاده میشود.
-
سنجش باکتریوفاژها: M17 Broth برای سنجش و شمارش باکتریوفاژهایی که استرپتوکوکهای لاکتیک را آلوده میکنند، کاربرد دارد.
-
جداسازی گونههای خاص: به دلیل ترکیبات خاص خود، به رشد گونههای دشوار و حتی جهشیافتههایی که قادر به تخمیر لاکتوز نیستند، کمک میکند.
-
صنایع لبنی: به دلیل اهمیت استرپتوکوکهای لاکتیک در تولید محصولات لبنی، این محیط در کنترل کیفیت و تحقیقات مرتبط با صنایع لبنی بسیار مهم است.
ترکیبات و طرز تهیه (نمونه فرمول عمومی):
M17 Broth شامل ترکیبات مختلفی است که نیازهای تغذیهای باکتریهای اسید لاکتیک را فراهم میکند. فرمولاسیون دقیق ممکن است بین تولیدکنندگان کمی متفاوت باشد، اما به طور کلی شامل موارد زیر است:
-
پپتونها (تریپتون، پپتون سویا، پپتون گوشت): منابع کربن، نیتروژن، ویتامینها و مواد معدنی ضروری برای رشد باکتری.
-
عصاره مخمر: منبع غنی از ویتامینهای گروه B که رشد باکتری را تحریک میکند.
-
لاکتوز: کربوهیدرات قابل تخمیر که توسط باکتریهای لاکتیک به اسید لاکتیک تبدیل میشود.
-
دیسدیم بتا-گلیسروفسفات: یک عامل بافری بسیار مهم که pH محیط را بالای 5.7 حفظ میکند. این امر از آسیب به استرپتوکوکهای لاکتیک در اثر تولید اسید و کاهش pH جلوگیری میکند. همچنین از رسوب با کلسیم مورد نیاز برای باکتریوفاژها جلوگیری میکند.
-
اسید اسکوربیک: یک عامل تحریککننده رشد برای استرپتوکوکهای لاکتیک.
-
سولفات منیزیم: فراهم کننده یونهای ضروری برای رشد.
m17 broth composition
طرز تهیه عمومی:
-
مقدار مشخصی از پودر محیط کشت M17 Broth (به عنوان مثال، 37.25 گرم یا 42 گرم) را در 950 تا 1000 میلیلیتر آب مقطر حل کنید.
-
به آرامی حرارت دهید و هم بزنید تا پودر کاملاً حل شود.
-
محیط را در لولههای آزمایش یا فلاسکهای مناسب بریزید.
-
محیط را با اتوکلاو کردن در دمای 121 درجه سانتیگراد و فشار 15 پوند به مدت 15 دقیقه استریل کنید.
-
پس از استریل شدن، اجازه دهید محیط خنک شود (معمولاً تا 50 درجه سانتیگراد).
-
اگر فرمولاسیون شما شامل افزودن لاکتوز به صورت جداگانه است، 50 میلیلیتر محلول استریل لاکتوز 10% (استریل شده با اتوکلاو یا فیلتراسیون) را به صورت آسپتیک به محیط خنک شده اضافه کرده و به آرامی مخلوط کنید.
شرایط نگهداری:
-
پودر خشک محیط کشت باید در دمای 10 تا 30 درجه سانتیگراد (یا 2-8 درجه سانتیگراد برای برخی از تولیدکنندگان) در یک ظرف در بسته و خشک نگهداری شود.
-
محیط کشت آماده شده باید در دمای 2 تا 8 درجه سانتیگراد نگهداری شود.
-
همیشه به تاریخ انقضای روی برچسب محصول توجه کنید.
نکات مهم:
-
حفظ pH مناسب برای رشد استرپتوکوکهای لاکتیک در این محیط بسیار حیاتی است.
-
قبل از استفاده، ظروف باید کاملاً تمیز و عاری از هرگونه آلودگی باشند.
-
آب مقطر مورد استفاده باید با کیفیت مناسب باشد.
-
دمای استریل کردن باید دقیقاً رعایت شود تا از تخریب مواد حساس به حرارت جلوگیری شود.
آدرس ایمیل شما منتشر نخواهد شد. فیلدهای الزامی علامت گذاری شده اند *